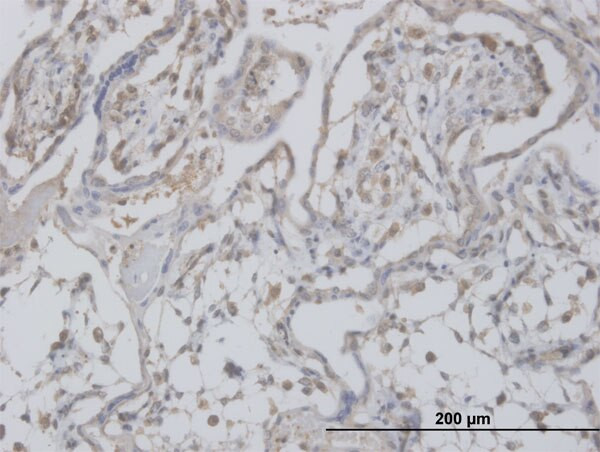
CLIC1 Antibody in Immunohistochemistry (Paraffin) (IHC (P))

Search
Abnova
CLIC1 Monoclonal Antibody (3F9)
{{$productOrderCtrl.translations['antibody.pdp.commerceCard.promotion.promotions']}}
{{$productOrderCtrl.translations['antibody.pdp.commerceCard.promotion.viewpromo']}}
{{$productOrderCtrl.translations['antibody.pdp.commerceCard.promotion.promocode']}}: {{promo.promoCode}} {{promo.promoTitle}} {{promo.promoDescription}}. {{$productOrderCtrl.translations['antibody.pdp.commerceCard.promotion.learnmore']}}
产品信息
H00001192-M02
宿主/亚型
分类
类型
克隆号
抗原
偶联物
形式
浓度
规格
保存条件
运输条件
产品详细信息
Sequence of this protein is as follows: MAEEQPQVEL FVKAGSDGAK IGNCPFSQRL FMVLWLKGVT FNVTTVDTKR RTETVQKLCP GGQLPFLLYG TEVHTDTNKI EEFLEAVLCP PRYPKLAALN PESNTAGLDI FAKFSAYIKN SSPALNDNLE KGLLKALKVL DNYLTSPLPE EVDETSAEDE GVSQRKFLDG NELTLADCNL LPKLHIVQVV CKKYRGFTIP EAFRGVHRYL SNAYAREEFA STCPDDEEIE LAYEQVAKAL K
靶标信息
Chloride channels are a diverse group of proteins that regulate fundamental cellular processes including stabilization of cell membrane potential, transepithelial transport, maintenance of intracellular pH, and regulation of cell volume. Chloride intracellular channel 1 is a member of the p64 family; the protein localizes principally to the cell nucleus and exhibits both nuclear and plasma membrane chloride ion channel activity.
仅用于科研。不用于诊断过程。未经明确授权不得转售。